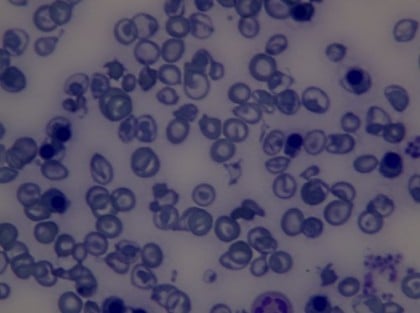
kullanıcı tarafından yüklenmiş görsel

1.
akdeniz ülkelerindeki toplumlarda görülen, doğacak çocuğa anne-babasından ”beta talasemi” geninin kalıtımsal olarak geçen bir tür kansızlık hastalığıdır.
kaynak
evlilik aşamasında resmi nikah için gerekli evraklar arasında talasemi testi sonucu her iki taraftan da istenir.
ukde idim doldum.
kaynak
evlilik aşamasında resmi nikah için gerekli evraklar arasında talasemi testi sonucu her iki taraftan da istenir.
ukde idim doldum.
devamını gör...
2.
bir diğer adı akdeniz anemisi olan hastalıktır.
devamını gör...
3.
(bkz: akdeniz anemisi)
ülkemizde yaklaşık 1.4 milyon taşıyıcısı ve 4500 hastası bulunan genetik miras.
hastalarda kırmızı kan hücreleri içinde bulunan solunum pigmentinin (bkz: hemoglobin) yapısı farklıdır ve görevini tam yapamaz. akciğerlerden hücrelere istenilen oranda oksijen taşıyamaz.
mersin, adana, hatay, antalya ve civar illerde hemen hemen her 10 kişiden biri taşıyıcıdır.
hastalık yunanistan, israil, suriye gibi ülkelerde de dünya geneline göre daha yaygındır.
4 tipi vardır. ikisi şöyle:
talasemi minör: taşıyı olma durumudur. hafif kanszılık ve halsizlik görülebilir. bu bireylerin eşleri de taşıyıcı ise 1/4 oranında çocuklarda ortaya çıkması beklenir.
talasemi major: akdeniz anemisinin en ağır şekli. kesin tedavisi kemik iliği naklidir. hastalar ömür boyu kan nakline ve bazı ilaçlara ihtiyac duyar.
ülkemizde yaklaşık 1.4 milyon taşıyıcısı ve 4500 hastası bulunan genetik miras.
hastalarda kırmızı kan hücreleri içinde bulunan solunum pigmentinin (bkz: hemoglobin) yapısı farklıdır ve görevini tam yapamaz. akciğerlerden hücrelere istenilen oranda oksijen taşıyamaz.
mersin, adana, hatay, antalya ve civar illerde hemen hemen her 10 kişiden biri taşıyıcıdır.
hastalık yunanistan, israil, suriye gibi ülkelerde de dünya geneline göre daha yaygındır.
4 tipi vardır. ikisi şöyle:
talasemi minör: taşıyı olma durumudur. hafif kanszılık ve halsizlik görülebilir. bu bireylerin eşleri de taşıyıcı ise 1/4 oranında çocuklarda ortaya çıkması beklenir.
talasemi major: akdeniz anemisinin en ağır şekli. kesin tedavisi kemik iliği naklidir. hastalar ömür boyu kan nakline ve bazı ilaçlara ihtiyac duyar.
devamını gör...
4.
kalıtsal yolla geçiş gösteren ve ileri derecede kansızlığa sebep olan bir hastalıktır. hastaların büyük bir kısmında kansızlık o kadar ileri seviyededir ki düzenli şekilde kan nakli yapılması gereklidir.
devamını gör...
5.
bilindik adıyla akdeniz anemisi dir. kalıtım yoluyla geçen ağır kansızlık sebebi olan genetik rahatsızlıktır.

beta talasemi majorlu bir hastanın periferik kan yaymasında eritrositlerin görünümü
ülkemizde bilinen 1,4 milyon talesemi hastalığının taşıyıcılığı 400 bin kadar da talesemi hastası olduğu bilinmektedir. genetik olan bu rahatsızlıkta hem kadın hem erkeğin taşıyıcı olması durumunda doğacak çocuğun %25 oranında hasta olma ihtimali vardır. kadınlarda olma olasılığı daha yüksek olan rahatsızlığın ileri derecede olanlarında düzenli kan transfüzyonu olmadan yaşam süresi ve yaşam kalitesi belirgin oranda düşmekte hatta hayatta kalama oranları oldukça düşmektedir.
iki çeşit talesemi vardır alfa ve beta . beta talesemi sıklıkla akdeniz bölgesinde görüldüğünden dolayı adına akdeniz anemisi denilmekte ve en tehlikeli olanıdır. talesemi kanda bulunan hemoglobin'in yapımındaki bozukluk ya da yetersizlik sonucu ortaya çıkmaktadır. kan nakli, kök hücre nakli, demir şalazyonu tedavisi gibi yöntemlerle tedavisi mümkün olan hastalık ; tam kan sayımı, hemoglobin elektroforezi, genetik tarama ve kan hücrelerinin incelenmesiyle teşhis edilebilir.
uzun yıllardır ülkemizde talesemi'nin engellenmesi için taramalar ve eğitimler verilmekte özellikle taşıyıcı bireylerin belirlenmesi için evlilik öncesinde talasemi taramaları yapılmaktadır. eğer ki hem kadın hem erkek taşıyıcı ise genetik eğitimler verilerek ve takipleri yapılarak talasemi hasta birey doğmasının önüne geçilebilmektedir. taşıyıcı olmak anne baba olmaya engel bir durum değildir .talesemi doğumdan birkaç hafta sonra belirti verebileceği gibi yetişkinlik dönemlerine kadar ciddi belirtilerde göstermeyebilir.
• akdeniz anemisi hastası olan bir birey, sağlıklı bir kişi ile evlenirse doğacak çocuklar sağlıklı taşıyıcılar olur.
• iki talasemi taşıyıcı evlenirse, doğacak çocuklar yüzde 50 ihtimalle taşıyıcısı, yüzde 25 ihtimalle hasta, yüzde 25 ihtimalle sağlıklı olur.
• talasemi hastası, talasemi taşıyıcısı olan bir bireyle evlenirse doğacak çocuklar yüzde 50 ihtimalle taşıyıcı veya hasta olur.
• talasemi taşıyıcısı, sağlam kişiyle evlenirse, doğacak çocukları yüzde 50 ihtimalle sağlam veya taşıyıcı olur.
• iki akdeniz anemisi hastası evlenirse, doğacak çocukların tümü hasta olur.
beta talasemi majorlu bir hastanın periferik kan yaymasında eritrositlerin görünümü
ülkemizde bilinen 1,4 milyon talesemi hastalığının taşıyıcılığı 400 bin kadar da talesemi hastası olduğu bilinmektedir. genetik olan bu rahatsızlıkta hem kadın hem erkeğin taşıyıcı olması durumunda doğacak çocuğun %25 oranında hasta olma ihtimali vardır. kadınlarda olma olasılığı daha yüksek olan rahatsızlığın ileri derecede olanlarında düzenli kan transfüzyonu olmadan yaşam süresi ve yaşam kalitesi belirgin oranda düşmekte hatta hayatta kalama oranları oldukça düşmektedir.
iki çeşit talesemi vardır alfa ve beta . beta talesemi sıklıkla akdeniz bölgesinde görüldüğünden dolayı adına akdeniz anemisi denilmekte ve en tehlikeli olanıdır. talesemi kanda bulunan hemoglobin'in yapımındaki bozukluk ya da yetersizlik sonucu ortaya çıkmaktadır. kan nakli, kök hücre nakli, demir şalazyonu tedavisi gibi yöntemlerle tedavisi mümkün olan hastalık ; tam kan sayımı, hemoglobin elektroforezi, genetik tarama ve kan hücrelerinin incelenmesiyle teşhis edilebilir.
uzun yıllardır ülkemizde talesemi'nin engellenmesi için taramalar ve eğitimler verilmekte özellikle taşıyıcı bireylerin belirlenmesi için evlilik öncesinde talasemi taramaları yapılmaktadır. eğer ki hem kadın hem erkek taşıyıcı ise genetik eğitimler verilerek ve takipleri yapılarak talasemi hasta birey doğmasının önüne geçilebilmektedir. taşıyıcı olmak anne baba olmaya engel bir durum değildir .talesemi doğumdan birkaç hafta sonra belirti verebileceği gibi yetişkinlik dönemlerine kadar ciddi belirtilerde göstermeyebilir.
• akdeniz anemisi hastası olan bir birey, sağlıklı bir kişi ile evlenirse doğacak çocuklar sağlıklı taşıyıcılar olur.
• iki talasemi taşıyıcı evlenirse, doğacak çocuklar yüzde 50 ihtimalle taşıyıcısı, yüzde 25 ihtimalle hasta, yüzde 25 ihtimalle sağlıklı olur.
• talasemi hastası, talasemi taşıyıcısı olan bir bireyle evlenirse doğacak çocuklar yüzde 50 ihtimalle taşıyıcı veya hasta olur.
• talasemi taşıyıcısı, sağlam kişiyle evlenirse, doğacak çocukları yüzde 50 ihtimalle sağlam veya taşıyıcı olur.
• iki akdeniz anemisi hastası evlenirse, doğacak çocukların tümü hasta olur.
devamını gör...
6.
ismini yunanca deniz anlamına gelen thalassa sözcüğüne "kanda bulunan, kanla ilgili" anlamı veren emi* son ekinin gelmesiyle alan bir tür niceliksel hemoglobinopati, hemoglobinin az üretilmesi* veya üretilememesi*. akdeniz civarı bölgelerde görüldüğü için bu isim verilmiş. kanda birkaç çeşit hemoglobin var, farklılıkları hemoglobin molekülünü oluşturan globinlerden kaynaklanıyor. yetişkin dönemde dominant hemoglobin hba, iki alfa ve iki beta altbiriminden oluşuyor. fetal dönemdeki hbf ise iki alfa iki gama altbiriminden. türkiye'de sık görülen beta talasemi major ve intermedia, beta altbirimin sentezindeki bozukluktan kaynaklanır* ve ilk üç ay yenidoğanda hbf varlığı yeterli olduğu için talasemi majorde bulgular hbf tükenmeye başlayıp hba'nın da üretilemediği üçüncü aydan sonra görülür, kan transfüzyonu almaya üç aydan sonra başlanır. intermediada ise iki yaşa kadar bulgular gözlenmeyebilir ve transfüzyon almaya iki yaştan sonra başlanabilir. ancak kan transfüzyonunun handikapı da demir birikimine neden olarak endokrin bozukluklara, kalple ilgili sorunlara yol açması ki beta talasemide en sık ölüm nedeni de demir birikimine bağlı kalp yetmezliğidir. bu yüzden talasemi majorde iki yaştan itibaren demir şelasyonu tedavisi verilir. tek küratif tedavi seçeneği ise kemik iliği naklidir.
devamını gör...